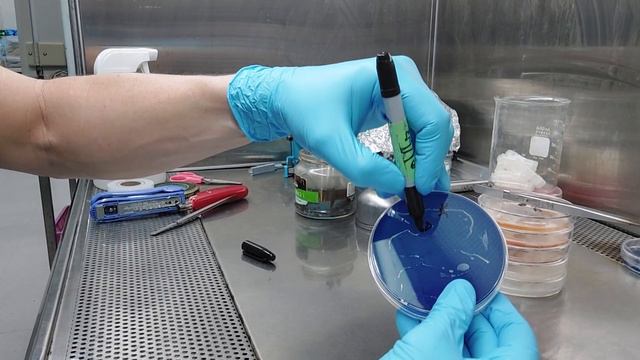
'Grab and Drag' Tek for isolating monokaryons and making T0 Multi-Spore (MS) spawn for phenohunting смотреть онлайн

Автор / Канал: Радость игровых киберспортивных турниров Страница 14

Spore Montage-Най Забавната Игра? :Д

Прохождение RimWorld / #2.7 Колония в тропическом климате. Комната для портного. Гусеница

SnowRunner : first epic fail mission on SeriesX (GamePass)

Мега заготовка мяса | The Long Dark
![Top 20 QUALITY OF LIFE Mods in RimWorld 1.1 [2020] смотреть онлайн Top 20 QUALITY OF LIFE Mods in RimWorld 1.1 [2020] смотреть онлайн](https://pic.rtbcdn.ru/video/9c/06/9c06a6f13d0162e717e1aecc521b8e87.jpg)
Top 20 QUALITY OF LIFE Mods in RimWorld 1.1 [2020]

EL NACIMIENTO DE LOS ARQUIZONIOS | SPORE 3 | EP. #1

The Forgotten City - (Xbox Game Pass) ep 06

Kroger grocery haul~large family~pantry challenge

Vídeos de Slime: Satisfatório & Relaxante

SnowRunner - MAZ 537 Rescue GAZ 69A & ROCA MZKT 741351 @ Cosmodrome

Portal Knights Multiplayer - Episode 25 - The Last Portals (Co-op Gameplay)

француз взорвался деревом

Spore Happy Feet

SIMCITY - Let´s play SimCity (2013) ◊ Helium/Ina Dorf Part 18 - Der einsame Baum (German / HD)

snowrunner

Jake Brakes on Kenworth T800 in Snowrunner ....!.??? BRUHHHHHH........

Episode 108: Transport Pod Launch! -- RimWorld: River Base

Vol. 1.1 | 2.25 Hrs - X MINUS ONE - Old Time Radio Drama - Science Fiction - Volume 1: Part 1 of 2

The great mining venture ~ Lets play RimWorld! Ep 35

Spore! (6) Squad WARFARE!

СТАРАЯ КАРГА С ВАЛЫНОЙ - The Long Dark#2
'Grab and Drag' Tek for isolating monokaryons and making T0 Multi-Spore (MS) spawn for phenohunting

Pokemon VC - Beating the Game in 5mins! (Dokokashira Door Glitch)

RIMWORLD 1.2 - #98 Verstärkung der Mauern - Royalty DLC - Let's Play - Deutsch
За каждым успешным каналом стоит личность, идея и сотни часов кропотливого труда. Если вы здесь, значит, автор «Радость игровых киберспортивных турниров» уже сумел зацепить ваше внимание своим уникальным стилем или подачей. А мы на RUVIDEO позаботились о том, чтобы вы могли изучить весь архив его работ в максимально комфортных условиях — без лишней суеты и преград.
Почему за работами канала «Радость игровых киберспортивных турниров» так интересно наблюдать? Всё просто: это честный контент, который находит отклик в сердцах зрителей. На нашем ресурсе вы можете смотреть онлайн все видео любимого автора бесплатно и в хорошем качестве. Нам важно, чтобы вы видели каждую деталь и слышали каждый нюанс, поэтому мы используем только стабильные плееры из открытых источников Rutube.
Следите за новинками канала, пересматривайте старые шедевры и открывайте для себя новые грани творчества «Радость игровых киберспортивных турниров». Мы постоянно обновляем ленту, чтобы у вас под рукой всегда были самые свежие выпуски. Никаких сложных регистраций — только вы и творчество, которое вдохновляет. Приятного вам путешествия по миру авторского контента на RUVIDEO!
Видео взято из открытых источников Rutube. Если вы правообладатель, обратитесь к первоисточнику.